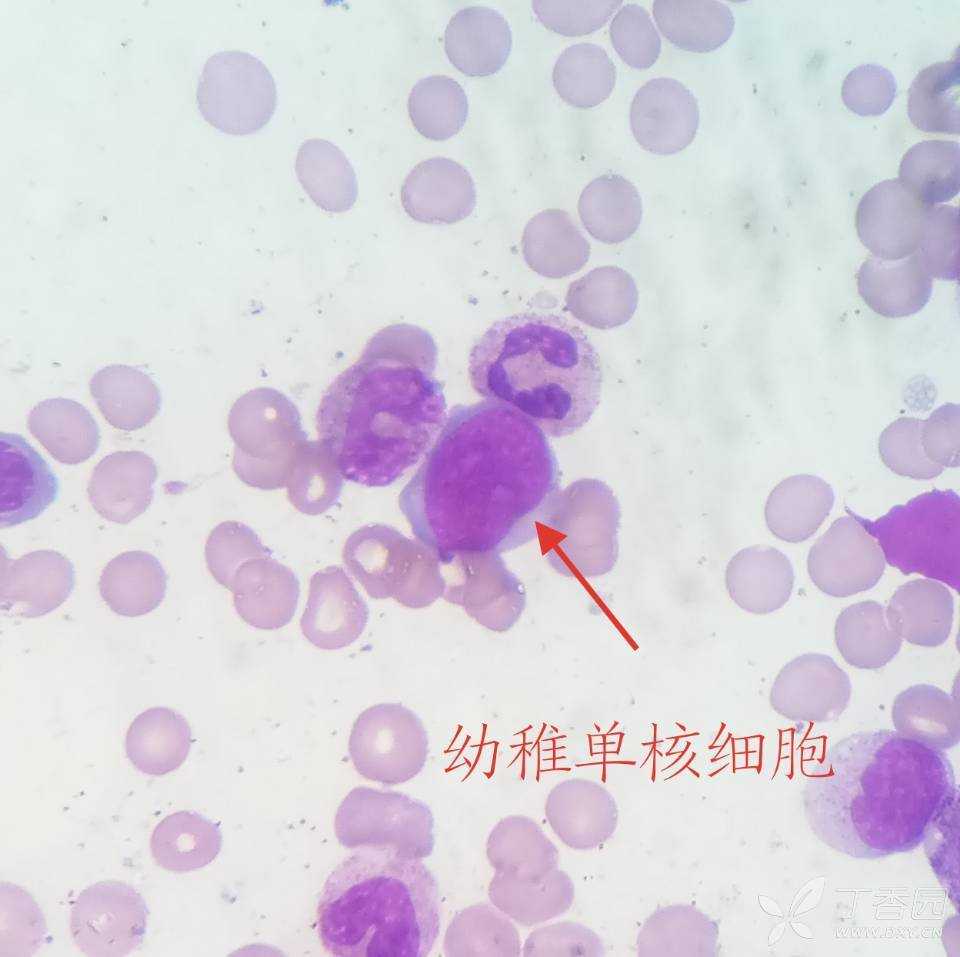
如何镜下区分淋巴细胞跟单核细胞 - 临床检验医学讨论版 - 专业医生社
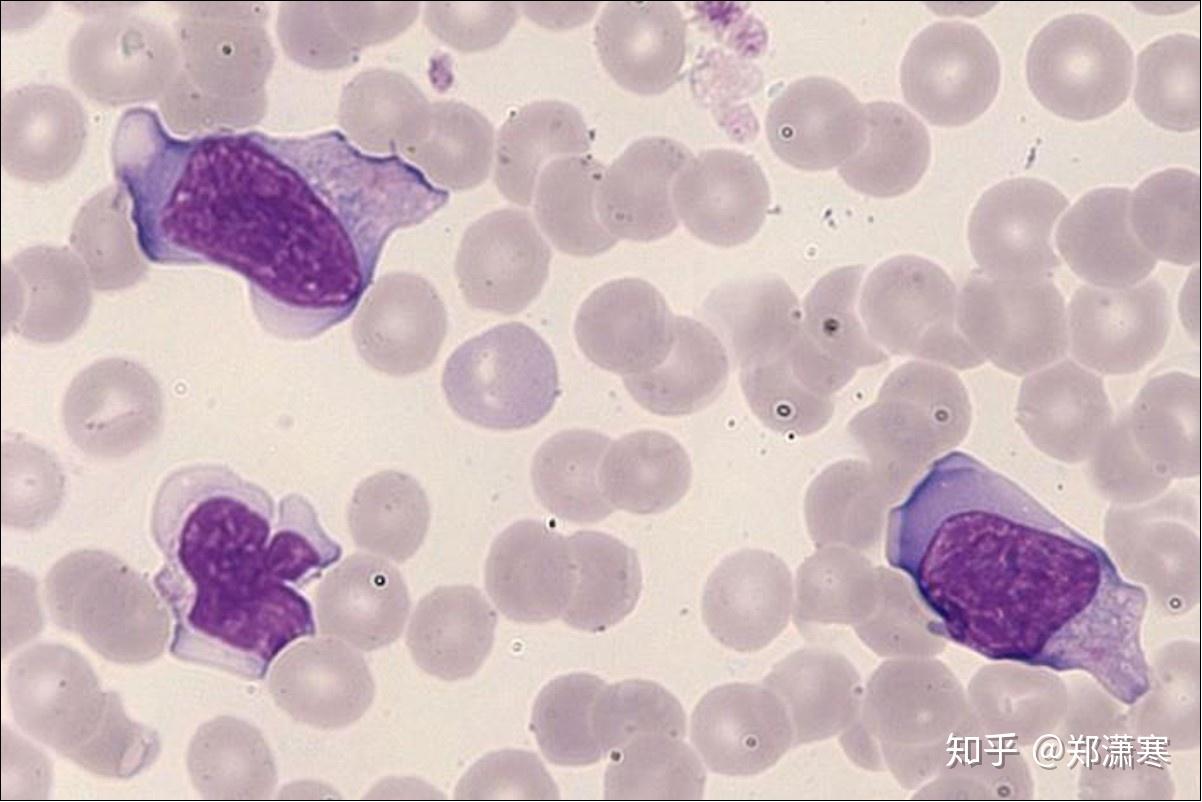
白细胞中单核细胞与淋巴细胞有什么关系传染性单核细胞增多症为什么会

淋巴细胞和单核细胞

血液及造血系统疾病基础ppt_word文档在线阅读与下载_免费文档
图片尺寸1080x810
20161222从浆白讨论 - 美篇
图片尺寸577x957
教你看懂血常规!(一)-搜狐
图片尺寸640x471
abo血型鉴定与血涂片观察 2014-3ppt_word文档在线阅读与下载_无忧文
图片尺寸1080x810
淋巴细胞末图为单核细胞#显微镜下的世界 #细胞 - 抖音
图片尺寸1440x2560
聊聊细胞分离和培养那些事儿-技术前沿-生物在线 lab-on-web
图片尺寸628x334
如何镜下区分淋巴细胞跟单核细胞 - 临床检验 -丁香园论坛
图片尺寸2668x2000
如何镜下区分淋巴细胞跟单核细胞 - 临床检验医学讨论版 - 专业医生社
图片尺寸960x957
01炎症 病理学_word文档在线阅读与下载_无忧文档
图片尺寸1080x810
左边是大淋巴细胞,右边是单核细胞.
图片尺寸1200x800
淋巴细胞系形态识别ppt_word文档在线阅读与下载_无忧文档
图片尺寸1080x810
如何镜下区分淋巴细胞跟单核细胞 - 临床检验医学讨论版 -丁香园论坛
图片尺寸2668x2000
b淋巴细胞讲解.ppt
图片尺寸1152x864
显微镜下的美丽血色景观_网易订阅
图片尺寸483x320
如何镜下区分淋巴细胞跟单核细胞 - 临床检验医学讨论版 -丁香园论坛
图片尺寸2668x2000
2012高中生物中图版必修3精品课件:1.4.1《人体免疫系统》.ppt_word文
图片尺寸1080x810
炎性细胞
图片尺寸640x481
【答案公布】根据血涂片,该患者最可能患何病?_经典病例_医脉通
图片尺寸900x602
白细胞中单核细胞与淋巴细胞有什么关系传染性单核细胞增多症为什么会
图片尺寸1202x802
t淋巴细胞结果的解读全国会吴铁军_文档下载
图片尺寸1080x810